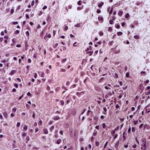

Bullous mastocytosis =داء الخلايا البدينة الفقاعي
mastocytosis Urticaria pigmentosa, although occasionally showing an autosomal dominant mode of transmission ( with a possible relationship to mutations in the KIT gene (310), in most instances occurs without a family history. It can be divided into four forms: (a) urticaria pigmentosa arising in infancy or early childhood without significant systemic lesions , (b) urticaria pigmentosa arising in adolescence or adult life without significant systemic lesions , (c) systemic mast cell disease, and (d) mast cell leukemia. |
In the first form, the cutaneous lesions often improve or even clear at puberty . Systemic lesions are absent as a rule and if present usually are few in number. Progression into systemic mast cell disease is very rare (see later). In the second form, urticaria pigmentosa arising in adolescence or adult life, systemic lesions are often present but as a rule are rather static in their course . However, spontaneous regression has never been documented in adults, in contrast to children . In only a few patients is there progression to the third form, systemic mast cell disease, which shows extensive and progressive involvement of intemal organs (see section on systemic lesions). The fourth form, mast cell leukemia, is very rare. It is characterized by the presence of cytologically malignant mast cells in many organs of the body, especially in the bone marrow and the peripheral blood, and is a rapidly fatal disease . Usually, there are no skin lesions . |
Patients with extensive mast cell infiltration of the skin or the internal organs commonly have attacks of flushing, palpitation, or diarrhea as a result of degranulation of mast cells and the release of histamine. |
Five types of cutaneous lesions are seen in urticaria pigmentosa . Two types can occur in both the infantile and the adult forms. First is the maculopapular type, the most common type, consisting usually of dozens or even hundreds of brown lesions that urticate on stroking (Fig. 6-38A); the second type exhibits multiple brown nodules or plaques and on stroking shows urtication and occasionally blister formation (Fig. 6-388). The third type, seen almost exclusively in infants, is characterized by a usually solitary, large cutaneous nodule, which on stroking often shows not only urtication but also large bullae. In rare instances, solitary nodules have been described as arising in adults without giving rise to bullae (318). The fourth type, the diffuse erythrodermic type, always starts in early infancy and shows generalized brownish red, soft infiltration of the skin, with urtication on stroking. Multiple blisters may form during the first 2 years of life on stroking and also spontaneously. If bullae are a predominant clinical feature, the term bullous mastocytosis has been applied . Although visceral lesions are common in the diffuse erythrodermic type, |
they usually improve and only very rarely progress to fatal systemic mast cell disease. On rare occasions, death occurs in early infancy, apparently as a result of histamine shock with no or with only insignificant mast cell infiltration of visceral organs (321). The fifth type of lesion, telangiectasia macularis eruptiva perstans, which usually occurs in adults, consists of an extensive eruption of brownish red macules showing fine telangiectasias, with little or no urtication on stroking . |
Histopathology . In all five types of lesions, the histologic picture shows an infiltrate composed chiefly of mast cells, which are characterized by the presence of metachromatic granules in their cytoplasm. These granules are not visible with routine stains but can be seen well after staining with a Giemsa stain or with toluidine blue. Also, the method using naphthol AS-D chloroacetate esterase, often called Leder’s method, makes mast cell granules appear red and thus quite conspicuous . |
In the maculopapular type and in telangiectasia macularis eruptiva perstans, the mast cells are limited to the upper third of the dermis and are generally located around capillaries. In some mast cells, the nuclei may be round |
or oval, but in most mast cells, they are spindle shaped . Because the mast cells may be present only in small numbers, and because in sections stained with hematoxylin-eosin their nuclei resemble those of fibroblasts or pericytes, the diagnosis may be missed unless special staining is employed . In cases with multiple nodules or plaques or with a solitary large nodule, the mast cells lie closely packed in tumor-like aggregates . The infiltrate may extend through the entire dermis and even into the subcutaneous fat . Whenever the mast cells lie in dense aggregates, their nuclei are cuboidal rather than spindle shaped, and they show ample eosinophilic cytoplasm and a well-defined cell border. Because of the shape of their nuclei and ample cytoplasm, they have a rather distinctive appearance, so the diagnosis usually can be made even before special staining has been carried out. |
In the diffuse, erythrodermic type, a dense, bandlike infiltrate of mast cells with a rather uniform appearance showing round to oval nuclei and a distinctly outlined cytoplasm is observed in the upper dermis . |
Eosinophils may be present in small numbers in all types of urticaria pigmentosa with the exception of telangiectasia macularis eruptiva perstans, in which eosinophils are generally absent because of the small numbers of mast cells within the lesions. If a biopsy is taken shortly after the lesion has been stroked, an increased number of eosinophils and extracellular mast cell granules are observed, which is an indication that granules have been released by the cells (327). |
The bullae that may occur in infants with multiple or solitary nodules or with the diffuse erythrodermic type arise subepidermally (328). Because of regeneration of the epidermis at the base of the bulla, older bullae may be located intraepidermally. The bullous cavity often contains mast cells as well as eosinophils . The pigmentation of lesions of urticaria pigmentosa is due to the presence of increased amounts of melanin in the |
basal cell layer and occasionally also of melanophages in the upper dermis. |
Systemic Lesions It is important to distinguish between asymptomatic systemic involvement of limited degree and true systemic mast cell disease, in which the lesions are symptomatic, widespread, and progressive. |
Asymptomatic systemic involvement of a limited degree may occur in urticaria pigmentosa of children, but it is not common. It occurs most commonly in the erythrodermic and nodular types and consists of bone and bone marrow involvement or of hepatosplenomegaly. In urticaria pigmentosa of adults, systemic lesions are more common. For instance, in routinely carried out bone marrow biopsies, as many as 75% of adult patients show mast cell infiltration of bone marrow in contrast to only 18% of children; radiologic survey of the skeleton has revealed bone changes in 44% of adult patients with urticaria pigmentosa but in only 5% of children (330). On radiologic examination, bones with mast cell infiltration may show areas of increased lucency intermingled with areas of increased density owing to the fact that mast cell aggregates in the bone marrow can cause focal bone resorption as well as reactive bone formation . |
In true systemic mast cell disease, massive infiltration of the bones may cause collapse of several vertebrae or a fracture of long bones . Myelofibrosis may occur, resulting in anemia, leukopenia, and thrombocytopenia (313). Pancytopenia may cause death. Systemic mastocytosis, besides involving the bone marrow and bones, generally involves various groups of lymph nodes and the liver and spleen, resulting in hepatosplenomegaly. In some cases, the gastrointestinal tract, lungs, and meninges are also infiltrated with mast cells . Mature mast cells may be found in the peripheral blood. |
Histogenesis. As seen by both light microscopy and electron microscopy, the mast cells of urticaria pigmentosa do not differ from normal mast cells either in structure or in mode of degranulation . Because mast cells contain histamine and release it during degranulation, chemical analysis of cutaneous lesions of urticaria pigmentosa reveals a considerably higher level of histamine than is found in normal skin . |
The increased melanin pigmentation in lesions of urticaria pigmentosa is the result of stimulation of epidermal melanocytes by mast cells. It is not caused by any substance present within the mast cells. In one case of nodular urticaria pigmentosa, however, some mast cells showed dual granulation containing both mast cell granules and melanosomes as well as granules representing intergrades between mast cell granules and melanosomes . |
Differential Diagnosis. Even if numerous mast cells are present, an absolutely reliable diagnosis of urticaria pigmentosa requires the demonstration of mast cell granules with the Giemsa stain, Leder’s method, or toluidine blue stain. On routine staining, the mast cells in macular lesions may resemble fibroblasts or pericytes, but those in nodular or erythrodermic lesions may resemble the histiocytes that are seen in Letterer-Siwe disease or in eosinophilic granuloma. Differentiation of urticaria pigmentosa from these two diseases on routine staining can be particularly difficult because in all three diseases, the infiltrate may contain eosinophils. In contrast with LettererSiwe disease, the cells of urticaria pigmentosa have no tendency to invade the epidermis. Occasionally, the cuboidal mast cells in nodular urticaria pigmentosa resemble nevus cells, but they show no tendency to lie in nests and show no junction activity. |
The macular type of urticaria pigmentosa, especially telangiectasia maculosa eruptiva perstans, occasionally may be difficult to diagnose even with the Giemsa stain because the number of mast cells may be so small that it does not differ significantly from the number normally present (330). Some inflammatory dermatoses, such as atopic dermatitis, lichen simplex chronicus, and lichen planus, may contain a high percentage of mast cells in their inflammatory cell infiltrates (337). However, in urticaria pigmentosa, the infiltrate consists exclusively of mast cells, except for a slight admixture of eosinophils as a result of the degranulation of some of the mast cells. |